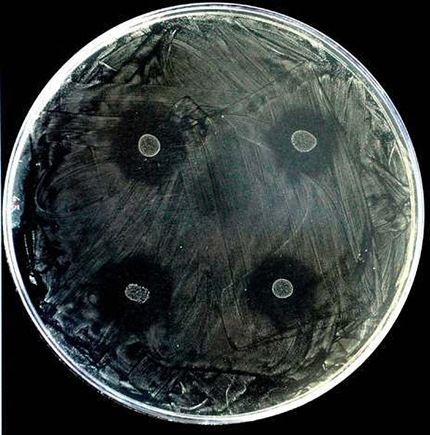
Bacteria anti caries

Descubren una bacteria capaz de evitar la caries
El equipo de científicos de la Fundación para el Fomento de la Investigación Sanitaria y Biomédica de la Comunidad Valenciana (Fisabio), de Valencia, España, dirigido por el investigador Alejandro Mira, ha determinado que la nueva especie de bacterias denominada “Streptococcus dentisani” trabaja como un “escudo” contra las caries.
Según informó la agencia RT, el principio del funcionamiento de “Streptococcus dentisani” hace que el microorganismo cree a su alrededor una zona de protección con una sustancia especial que no deja crecer a las bacterias.
![]() |
Los autores del hallazgo ya lograron patentar el uso de la nueva bacteria anticaries en la Consejería de Sanidad de la Comunidad Valenciana, y ahora están buscando una salida comercial en empresas del sector alimentario y de productos de higiene dental.
De acuerdo con los científicos, el descubrimiento podría ponerse en un futuro próximo a disposición de la población en forma de yogur, chicle o enjuague bucal.
El presidente del Colegio de Odontólogos de Valencia, Enrique Llobell, por su parte, calificó el nuevo hallazgo de "el mayor avance de la odontología desde que empezó a utilizarse el titanio para los implantes".